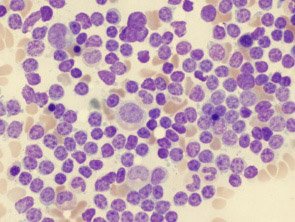

Uma terapia experimental baseada na reprogramação genética de células T do próprio sistema imunológico trouxe remissão prolongada para pacientes de leucemia linfoblástica aguda, após falha dos tratamentos convencionais.
Uma terapia experimental baseada na reprogramação genética de células T do próprio sistema imunológico trouxe remissão prolongada para pacientes de leucemia linfoblástica aguda, após falha dos tratamentos convencionais.
O estudo foi realizado por pesquisadores do Hospital Infantil da Filadélfia e do Hospital da Universidade da Pensilvânia. Os principais resultados foram publicados no The New England Journal of Medicine (vol. 371:1507-1517).
A pesquisa incluiu 30 pacientes de LLA, sendo cinco adultos, com idades entre 26 e 60 anos, e 25 crianças e jovens adultos, com idades entre 5 e 22 anos, todos gravemente doentes. Mais da metade dos pacientes apresentava recorrência da doença, mesmo depois de um transplante de células-tronco, e a expectativa de vida era de poucos meses, ou em alguns casos, apenas de algumas semanas. No entanto, seis meses após o tratamento, 23 dos 30 pacientes ainda estavam vivos, e 19 deles permanecem em remissão completa.
O estudo foi liderado por Stephan A. Grupp, para quem os resultados excederam as expectativas. Pesquisa semelhante, também com resultados encorajadores, está sendo realizada no Memorial Sloan Kettering Cancer Center, em Nova York.
“Temos um número de pacientes que estão há mais de um ano em remissão e não requerem outras terapias", disse Grupp. O agente havia demonstrado bons resultados em um pequeno grupo de pacientes com leucemia mieloide crônica. Agora, essas primeiras análises mostram que o tratamento também alcançou resultados reais na forma aguda da doença.
Atualmente, a leucemia linfoblástica aguda tem uma taxa de cura em adultos de apenas cerca de 40%, comparada com 80% a 90% em crianças.
Resultados
O tratamento experimental usa as próprias células T presentes no sistema imunológico dos pacientes. Os pesquisadores extraem as células-T, que, em seguida, são manipuladas geneticamente. O novo material genético reprograma as células T, que passam a reconhecer e matar células associadas à proteína CD19, um tipo de proteína encontrada nas células-B do sistema imune, normalmente afetadas pela leucemia.
O tratamento claramente não funciona para todos. Sete dos 30 pacientes morreram, incluindo alguns que tiveram remissão completa no início e depois uma recaída. Em três anos, a leucemia voltou em células B que não tinham a proteína CD19 e, portanto, não eram o alvo do tratamento.
Dos 19 pacientes que estão em remissão, 15 permanecem sem qualquer tratamento adicional com um período de acompanhamento médio de sete meses. Remissões sustentadas foram alcançadas até dois anos, com seis meses de sobrevida livre de eventos em 67% da amostra (IC 95%, 51% a 88%) e sobrevida global em 78% (IC 95%, 65% e 95%).
Todos os pacientes apresentaram síndrome de liberação de citoquinas. Dos 30 pacientes tratados, 74% (n = 22) sofreram síndrome leve a moderada, enquanto 27% dos pacientes (n = 8) apresentaram sintomas mais severos da síndrome.
Grupp disse que as longas remissões sugerem que o tratamento com células T pode no futuro representar um potencial substituto para os transplantes de células-tronco.
Em julho, a Food and Drug Administration considerou o tratamento de células T como "terapia inovadora" (breakthrough therapy) para a leucemia linfoblástica aguda recorrente ou resistente, em adultos e crianças. A designação reconhece drogas experimentais que podem demonstrar benefícios em relação às terapias existentes.
O quinto pilar
Durante a última década, terapias-alvo, como imatinibe (Glivec ®) e trastuzumabe (Herceptin®) desafiaram os pilares clássicos da oncologia, até então apoiados na cirurgia, quimioterapia e radioterapia. Agora, é a vez da imunoterapia promover uma verdadeira revolução, que já começa a ser considerada o quinto pilar no tratamento do câncer.
Os resultados dos ensaios realizados até agora "são a prova de princípio de que podemos alterar com sucesso as células T dos pacientes para atacar as células cancerosas", dizem os pesquisadores.
Após a coleta, as células T são geneticamente modificadas para produzir receptores especiais em sua superfície, os chamados receptores de antígeno quimérico. Esses receptores são proteínas que permitem que as células T reconheçam uma proteína específica, neste caso a CD19 presente nas células tumorais.
A farmacêutica Novartis ajudou a financiar o estudo.
Referências: http://www.nejm.org/doi/full/10.1056/NEJMoa1407222




